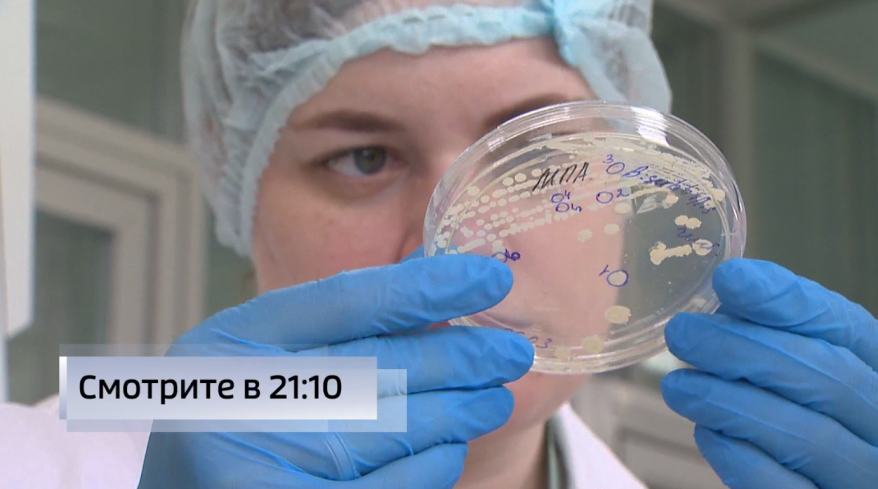

Уникальные активаторы жизни разработали приморские ученые
Настоящие активаторы жизни, способные творить чудеса, разработали дальневосточные ученые! Пробиотики нового поколения из Приморья скоро появятся на российском рынке!
Анна Подволоцкая, кандидат медицинских наук, декан факультета биоэкономика и биобезопасность Передовой инженерной школы ДВФУ: "Это — кормовая пробиотическая добавка, у нас уже под нее есть линия, мы ее будем получать тоннами. Уже подобраны питательные среды…"
В термостатах наращивают массу уникальные штаммы. В комплексе с полисахаридами из дальневосточных биоресурсов, ноу-хау сможет улучшить качество кормов и безопасность продукции животноводства.
Егор Рочин, главный биотехнолог, старший преподаватель Передовой инженерной школы ДВФУ: "Мы разрабатываем собственный ассортимент пробиотиков с использованием отечественных штаммов микроорганизмов, выделенных из естественных источников".
Смогут ли уникальные биодобавки вытеснить антибиотики, применяемые в животноводстве? Какие пробиотики для лечебного питания человека также появятся на российском рынке? Об этом смотрите сюжет сегодня, 4 июня, в 21:10 в программе "Вести: Приморье" на телеканале "Россия-1".